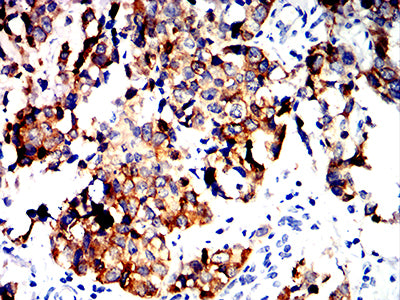

Mouse Monoclonal Antibody to ALDH1L1
货号:
32286
别名:
FDH; FTHFD; 10-fTHF; 10-FTHFDH
应用:
WB,IHC,FCM
反应种属:
Human, Mouse, Rat
抗体类型:
Primary antibody
Swissprot:
O75891
规格:
目录价
在线咨询
Description |
|---|
The protein encoded by this gene catalyzes the conversion of 10-formyltetrahydrofolate, nicotinamide adenine dinucleotide phosphate (NADP+), and water to tetrahydrofolate, NADPH, and carbon dioxide. The encoded protein belongs to the aldehyde dehydrogenase family. Loss of function or expression of this gene is associated with decreased apoptosis, increased cell motility, and cancer progression. There is an antisense transcript that overlaps on the opposite strand with this gene locus. Alternative splicing results in multiple transcript variants. |
References |
|---|
| 1.Chem Biol Interact. 2017 Oct 1;276:23-30. 2.Oncotarget. 2016 Aug 2;7(31):49397-49410. |
Specification |
|
|---|---|
| Aliases | FDH; FTHFD; 10-fTHF; 10-FTHFDH |
| Entrez GeneID | 10840 |
| Swissprot | O75891 |
| clone | 1B5E1 |
| WB Predicted band size | 98.8kDa |
| Host/Isotype | Mouse IgG1 |
| Antibody Type | Primary antibody |
| Storage | Store at 4°C short term. Aliquot and store at -20°C long term. Avoid freeze/thaw cycles. |
| Species Reactivity | Human, Mouse, Rat |
| Immunogen | Purified recombinant fragment of human ALDH1L1 (AA: 10-222) expressed in E. Coli. |
| Formulation | Purified antibody in PBS with 0.05% sodium azide |
Application |
|
|---|---|
| WB | 1/500 - 1/2000 |
| IHC | 1/200 - 1/1000 |
| FCM | 1/200 - 1/400 |
| ELISA | 1/10000 |
Product Image
-
Black line: Control Antigen (100 ng);Purple line: Antigen (10ng); Blue line: Antigen (50 ng); Red line:Antigen (100 ng)

-
Western blot analysis using ALDH1L1 mouse mAb against Rat kidney (1), Mouse liver (2), Rat liver (3) and Mouse kidney (4) tissue lysate.

-
Flow cytometric analysis of Jurkat cells using ALDH1L1 mouse mAb (green) and negative control (red).

-
Immunohistochemical analysis of paraffin-embedded human liver cancer tissues using ALDH1L1 mouse mAb with DAB staining.

-
Immunohistochemical analysis of paraffin-embedded human bladder cancer tissues using ALDH1L1 mouse mAb with DAB staining.

鄂公网安备42018502007531号

